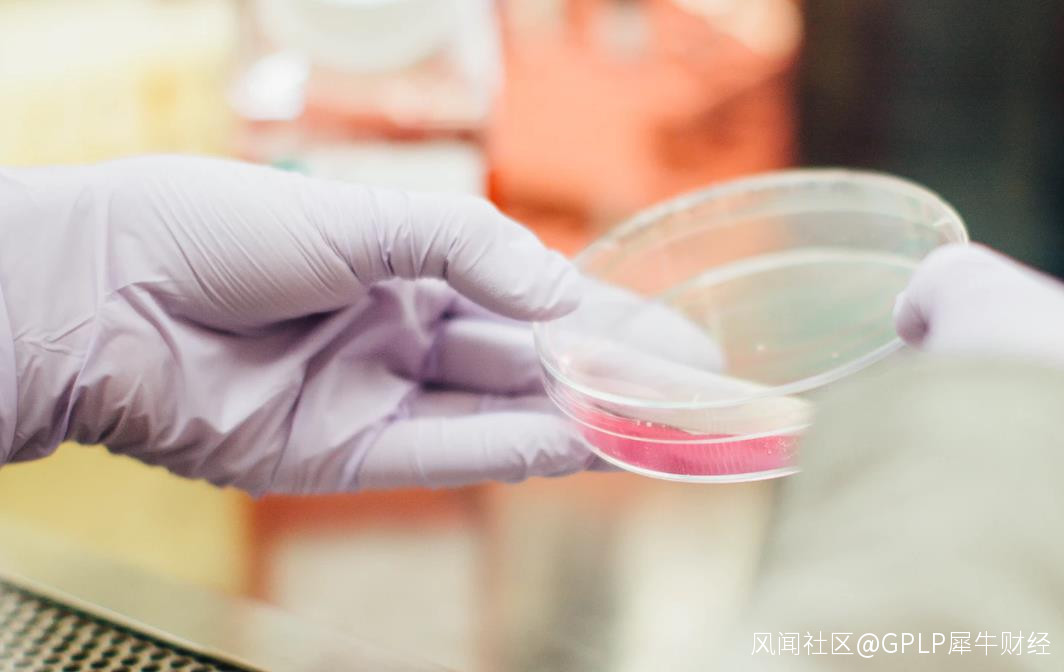

龍津藥業第三大股東擬減持4% 業績預降七成股價逆勢持續下跌_風聞
GPLP-GPLP犀牛财经官方账号-专业创造价值!2020-02-19 19:48
作者:東風
來源:GPLP犀牛財經(ID:gplpcn)
2020年以來,醫藥板塊成為A股漲幅冠軍,然而龍津藥業(002750.SZ)股價卻逆勢下跌。
2月18日,龍津藥業發佈公告稱,第三大股東惠鑫盛擬減持不超過1602萬股,佔總股本4.00%。減持後,惠鑫盛持股將由5.32%降至1.32%。
公告顯示,龍津藥業4名高管樊豔麗、李亞鶴、楊瑞仙、蔡海萍同為惠鑫盛股東。天眼查數據顯示,這4人分別持有惠鑫盛4.22%、5.07%、2.53%、1.69%股份。
龍津藥業成立於1996年,於2015年在深交所上市,重要業務為中西藥的研發、生產及銷售。
經GPLP犀牛財經統計,2019年6月以來,龍津藥業高管及大股東共進行了13次減持,累計達2063萬股,其中兩筆減持來自董事長樊獻俄,共107萬股。值得注意的是,樊獻俄2017年、2018年共進行了25次增持,累計達428萬股。
龍津藥業2019年第一季度扭虧為盈,實現歸母淨利潤523.74萬元,同比增長4.48%。其行情從2月1日啓動,4月12日達到最高價23.42元/股,漲幅高達316%。
龍津藥業2019年上半年實現歸母淨利潤降至134.01萬元,同比下滑87.73%,而該公司高管及大股東的密集減持正好從2019年6月開始。
然而龍津藥業2019年第三季度業績並沒有好轉,2019年第三季度實現歸母淨利潤46.58萬元,同比下滑87.07%;前三季度實現淨利潤180.59萬元,同比降87.57%。此外,中央匯金也退出前十大流通股股東之列。
(來源:Wind)
龍津藥業公告顯示,預計2019年實現歸屬於上市公司股東的淨利潤為404.14萬-606.21萬元,同比降 70.86%至 56.29%。
2020年以來,A股醫藥板塊全線上漲,而龍津藥業卻不漲反跌。截至2020年2月19日,龍津藥業收報11.78元/股,跌幅4.23%,與2019年12月31日收盤價12.87元/股相比,年內跌幅8.45%。